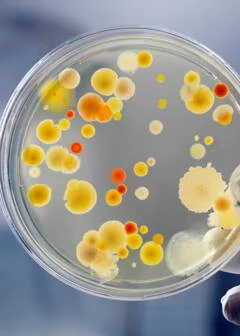

Homme et vie - Environnement - Agriculture - Culture générale - Monde d'Animal
décembre 20, 2024
MONDE D'ANIMAL ( Chat sauvage Felis silvestris )
Le chat sauvage (Felis silvestris) est un mammifère de la famille des Félidés. On le trouve dans certaines prairies, forêts, savanes et déserts en Eurasie et en Afrique. Carnivore, il se nourrit de divers petits animaux.
Sommaire
Taxonomie du chat sauvage
Caractéristiques physiques du chat sauvage
Performances physiques du chat sauvage
Écologie et répartition du chat sauvage
Régime alimentaire du chat sauvage
Mode de vie du chat sauvage
Reproduction du chat sauvage
Menaces et conservation du chat sauvage
Photos du chat sauvage
-Taxonomie du chat sauvage
Classification
Règne : Animal
Embranchement/sous-embranchement : Chordé vertébré
Classe : Mammalia
Ordre : Carnivora
Famille : Felidae felinae
Genre : Felis
Espèce : silvestris
Nom scientifique : Felis silvestris
Sous-espèces / taxons
Selon les dernières études, on distingue 5 à 6 sous-espèces de chat sauvage :
Liste des sous-espèces
Chat ganté (Felis silvestris lybica)
Chat sauvage d’Afrique subsaharienne (Felis silvestris cafra)
Chat orné (Felis silvestris ornata)
Chat de Biet (Felis silvestris bieti), parfois considérée comme une espèce
Chat forestier ou chat sauvage d’Europe (Felis silvestris silvestris)
Chat domestique (Felis silvestris catus)
Auparavant et encore aujourd’hui dans certaines classifications, on compte diverses autres sous-espèces.
En Afrique :
Felis silvestris cafra (Afrique du Sud)
Felis silvestris foxi (Afrique de l’Ouest)
Felis silvestris griselda (Afrique centrale)
Felis silvestris lybica (Afrique du Nord)
Felis silvestris ocreata (Afrique du centre-est)
Felis silvestris mellandi (Afrique du centre-ouest)
Felis silvestris ugandae
En Asie et au Moyen-Orient :
Felis silvestris caudata (Mer Caspienne)
Felis silvestris ornata (de l’Iran à Inde)
Felis silvestris bieti (Chine)
Felis silvestris iraki (Moyen-Orient)
En Europe :
Felis silvestris cretensis (Crête) (presque certainement éteint)
Felis silvestris caucasica (Caucase et Turquie)
Felis silvestris grampia (Écosse)
Felis silvestris jordansi (Îles Baléares)
Felis silvestris reyi (Corse) (probablement éteint)
Felis silvestris silvestris (Europe)
Autres:
Felis silvestris chutuchta
Felis silvestris gordoni
Felis silvestris haussa
Felis silvestris nesterovi
Felis silvestris rubida
Felis silvestris tristrami
Felis silvestris vellerosa
Caractéristiques physiques du chat sauvage
Taille
Longueur : 50 à 80 cm de long.
Queue : 25 à 38 cm en moyenne.
La taille varie grandement selon la région. Les mâles sont en moyenne un peu plus grands que les femelles.
Poids
Femelle : 3,5 kg environ.
Mâle : 5 à 8 kg
Le poids varie selon la saison (jusqu’à 2,5 kg d’écart entre l’été et l’hiver) et selon la région (les chats africains sont en moyenne moins lourds).
Morphologie et apparence
Le chat sauvage est un petit félin qui possède un corps allongé assez robuste, des pattes fines mais puissantes munies de coussinets et de griffes rétractiles ainsi qu’une longue queue large, touffue et non effilée. Son museau est légèrement profilé, sa tête arrondie, ses grandes oreilles triangulaires arrondies et ses yeux perçants bleus ou verts, dotés d’une pupille féline (lui permettant de voir dans la pénombre).
Ses longues vibrisses lui permettent de se repérer dans son environnement. Le bout de son museau est rose. Quelques différences physiques séparent les différentes sous-espèces (taille, forme du corps, nuances du pelage, …). A l’inverse du chat domestique qui possède un poil avec des couleurs et des motifs variés, le chat sauvage possède une robe précise. Son épais pelage est beige à marron gris, avec des rayures brun foncé à noires sur le corps, en particulier sur la queue (annelée).
Performances physiques du chat sauvage
Vitesse
Le chat sauvage patrouille à 6–10 km/h environ et peut atteindre des pointes à 45 km/h.
Écologie et répartition du chat sauvage
Aire de répartition
Le chat sauvage vit dans quelques régions d’Europe et d’Asie, ainsi qu’un peu partout en Afrique.
Liste des pays
Présent
Afghanistan ; Albanie ; Algérie ; Andorre ; Angola ; Arménie ; Autriche ; Azerbaïdjan ; Biélorussie ; Belgique ; Bénin ; Bosnie-Herzégovine ; Botswana ; Bulgarie ; Burkina Faso ; Burundi ; Cameroun ; République Centrafricaine ; Tchad ; Chine ; Congo ; République Démocratique du Congo ; Croatie ; Allemagne ; Djibouti ; Égypte ; Érythrée ; Eswatini ; Éthiopie ; France ; Gambie ; Géorgie ; Ghana ; Gibraltar ; Grèce ; Guinée ; Guinée-Bissau ; Hongrie ; Inde ; Iran ; Irak ; Israël ; Italie ; Jordanie ; Kazakhstan ; Kenya ; Koweït ; Kirghizistan ; Lettonie ; Liban ; Lesotho ; Libye ; Lituanie ; Luxembourg ; Malawi ; Mali ; Mauritanie ; Moldavie ; Mongolie ; Monténégro ; Maroc ; Mozambique ; Namibie ; Niger ; Nigeria ; Macédoine du Nord ; Oman ; Pakistan ; Pologne ; Portugal ; Roumanie ; Fédération de Russie ; Rwanda ; Arabie Saoudite ; Sénégal ; Serbie ; Sierra Leone ; Slovaquie ; Slovénie ; Somalie ; Afrique du Sud ; Sud-Soudan ; Espagne ; Soudan ; Suisse ; Syrie ; Tadjikistan ; Tanzanie ; Togo ; Tunisie ; Turquie ; Turkménistan ; Ouganda ; Ukraine ; Emirats Arabes Unis ; Royaume-Uni ; Ouzbékistan ; Sahara occidental ; Yémen ; Zambie ; Zimbabwe
Éventuellement éteint
Tchéquie
Éteint
Pays-Bas
Présence incertaine
Côte d’Ivoire
Habitat
Le chat sauvage vit dans les prairies tempérées et les savanes tropicales, mais aussi dans les forêts tempérées, les bois méditerranéens et les déserts rocheux.
Régime alimentaire du chat sauvage
Type de régime
Carnivore
Nourriture et proies
Le chat sauvage se nourrit principalement de petits animaux comme les rongeurs, les mulots, les campagnols, les lièvres, les loirs et les souris des champs. Il s’attaque également aux petits carnivores (hermine, belette, martre) et aux faons de cerfs élaphes, de chevreuils et de chamois. Il mange également des oiseaux, notamment des oiseaux aquatiques (fauvettes, canards), des petits reptiles et des écrevisses.
Mode de vie du chat sauvage
Vie sociale
Le chat sauvage est un animal solitaire, qui possède un territoire délimité qu’il marque (déjections, traces de griffes) et qu’il défend face aux autres chats. C’est seulement à la reproduction que mâles et femelles interagissent, restant ensemble quelque temps.
Territoire
La taille du territoire est très variable selon la région et le sexe (ceux des mâles sont plus grands que ceux des femelles), d’en moyenne 3 km2.
Comportement
L’activité du chat sauvage varie selon la sous-espèce. En effet, les chats sauvages d’Europe et d’Asie dans les zones peu urbanisées sont principalement diurnes, tandis que les chats africains sont principalement nocturnes. Grand marcheur, ce félin parcoure jusqu’à 10 km par nuit à la recherche de nourriture. Pour se reposer, il se cache dans le creux d’un arbre, une fissure rocheuse ou un terrier/nid abandonné.
Très agile, le chat sauvage peut facilement grimper aux arbres pour chasser ou se cacher des prédateurs. C’est en effet un animal farouche, qui fuit généralement au moindre danger.
Technique de chasse
Le chat sauvage chasse à l’affût, utilisant notamment l’obscurité pour surprendre ses proies. Il s’approche de sa proie doucement, puis se jette sur elle ou la poursuit pour la tuer d’une morsure à la gorge ou d’un coup de griffe.
Communication et vocalises
Les chats sauvages communiquent entre eux grâce aux sons, aux odeurs et aux postures. Les adultes communiquent à travers des sifflements et des miaulements, en déposant des marquages olfactifs et en adoptant des postures (poils hérissés, mouvements de queue, dos rond). Les mères communiquent avec leurs petits grâce à des ronronnements et des couinements.
Prédateurs
Les principaux prédateurs du chat sauvage sont le renard roux, le loup gris, les hiboux, les faucons et même d’autres chats plus grands (sauvages ou domestiques).
Longévité
L’espérance de vie du chat sauvage est de :
A l’état sauvage : 15 ans environ (bien que beaucoup meurent avant 1 an).
En captivité : jusqu’à 30 ans.
Reproduction du chat sauvage
Type de reproduction
Vivipare
Habitudes reproductives
Polygame
Période de reproduction
La saison des amours du chat sauvage dépend de la sous-espèce et de la région :
En Europe : janvier à mars.
En Asie et Afrique : septembre à mars.
Accouplement
L’accouplement a lieu sur le sol ou le toit d’une maison, à l’aube ou lors d’une nuit lumineuse (lune).
Maturité sexuelle
Le chat sauvage est sexuellement mature à :
Femelle : 10 à 11 mois.
Mâle : 9 à 22 mois.
Gestation
56 à 68 jours environ.
Lieux de mise bas
La femelle accouche dans un terrier, dans la végétation ou sous les rochers.
Nombre de petits
La chatte met bas 1 à 8 petits, 3 ou 4 en moyenne, à raison d’une portée par an (parfois 2 si la première est perdue).
Apparence des petits
A la naissance, les jeunes chats sauvages sont aveugles et ne peuvent pas marcher. Ils ouvrent leurs yeux à 10 jours.
Sevrage et éducation
Les chatons sont élevés uniquement par leur mère qui les allaite pendant 30 jours. Celle-ci les élève dans la tanière pendant 4 à 12 semaines. Ils apprennent ensuite à chasser auprès d’elle jusqu’à 4 à 10 mois, âge de leur indépendance.
Menaces et conservation du chat sauvage
Danger d'extinction (Statut UICN)
Le chat sauvage est une Préoccupation mineure (LC) selon l’UICN.
Population
Le nombre de chats sauvages à l’état sauvage est actuellement inconnu. On sait cependant que leur population est actuellement en baisse.
Menaces
Les menaces pesant sur le chat sauvage sont principalement locales. Elles sont les suivantes :
Déforestation et urbanisation qui contribuent à la disparition de l’espèce dans certaines régions.
Croisements avec le chat domestique.
Maladies et virus transmis par le chat domestique.
Collisions routières.
VOTRE SANTE D'ABORD ( Grippe A : en ce moment, durée, contagion, c'est quoi ? )
Les cas de grippe augmentent depuis décembre. Le virus de type A circule majoritairement mais qu'est-ce que c'est ?
-Sommaire
Définition
Symptômes-Incubation
Contagion
Durée de la grippe A
Traitements
-Après quelques années de répit liées à la présence du virus du Covid-19, celui de la grippe est de retour en décembre 2024. Semaine après semaine, les bulletins épidémiologiques de Santé Publique France confirment l'augmentation des cas de grippe, particulièrement chez les moins de 15 ans. Plusieurs types de virus de la grippe peuvent circuler mais si l'on en croit le bulletin publié en décembre c'est le sous-type A de la grippe qui prédomine.
-
-Qu'est-ce que la grippe A ?
La grippe est une maladie infectieuse provoquée par des virus appelés "virus influenza". Ils appartiennent à la famille des Orthomyxoviridae. Il existe quatre types de virus influenza pouvant provoquer la grippe : A, B, C et D. Les trois types A, B et C sont capables d'infecter l'Homme mais seuls les types A et B sont à l'origine des épidémies de grippe saisonnière. Le virus D n'infecte que l'animal. "Les virus de la grippe A sont les seuls connus pour provoquer des pandémies de grippe (le virus peut s'étendre au monde entier), du fait de leur pouvoir de propagation élevé et d'une faible ou absence d'immunité contre ces virus chez les personnes infectées" rappelle la Haute Autorité de Santé. Les virus A sont eux-même classés en sous-types ou "souches" selon les caractéristiques de protéines présentes à leur surface : les protéines "hémagglutinine" (HA ou H) et "neuraminidase" (NA ou N). Seuls deux sous-types de la grippe A circulent dans la population humaine : H1N1 et H3N2. Ils peuvent circuler simultanément au cours d'une même épidémie saisonnière.
-Quels symptômes ? Au bout de combien de temps ?
L'incubation du virus de la grippe est très courte, un à deux jours seulement. Le virus cible alors les cellules épithéliales du système respiratoire. Il s'y multiplie activement et diffuse du rhinopharynx vers les voies respiratoires inférieures. C'est la réponse inflammatoire de l'organisme qui explique l'apparition brutale des symptômes de la grippe : fièvre (39-40°C), frissons, maux de tête, nez qui coule, mal de gorge, toux... Il peut aussi exister des formes plus atténuées de grippe.
Quelle est la durée de contagion ?
La période de contagion de la grippe est d'une bonne semaine. "Le malade est contagieux dès l'incubation (donc 1 à 2 jours avant le début des symptômes, ndlr) et ce durant une période d'environ 6 jours pouvant aller jusque 10 jours, notamment chez les enfants" nous précisait le Dr Laurence Legout, médecin infectiologue à la Clinique du Verger en Suisse dans un article sur la grippe A (H1N1). La transmission du virus se fait par voie aérienne. "La personne contaminée projette des gouttelettes de salive dans l'air en toussant, en parlant, en éternuant. Ces gouttelettes contenant des millions de virus se retrouvent dans l'air ambiant vont être inhalées et respirées par une personne non malade qui va à son tour être malade" poursuit le Dr Legout. D'où l'importance d'aérer régulièrement les espaces fermés et de porter un masque quand on est malade.
Combien de temps dure la grippe A ?
L'élimination du virus se fait en 7 à 10 jours. La personne va mieux au bout d'une semaine mais une fatigue post-grippale accompagnée parfois de toux peut perdurer plusieurs semaines.
Quels traitements ?
La grippe se soigne avec du repos et du paracétamol en cas de fièvre, maux de tête et courbatures (jamais d'aspirine, surtout chez l'enfant). Des remèdes naturels peuvent aussi aider à booster l'organisme comme le jus de citron, des tisanes de thym, la diffusion d'huiles essentielles de niaouli, de ravintsara ou d'eucalyptus radié pour assainir l'air ambiant et dégager les voies respiratoires.
-Attention, si l'état de santé empire au lieu de s'améliorer au fil des jours, il faut consulter ou reconsulter. Les complications les plus fréquentes de la grippe sont respiratoires : pneumonie virale ou bactérienne. La grippe peut entraîner des détresses respiratoires graves avec mise en jeu du pronostic vital. L'hospitalisation est nécessaire avec la mise en place de traitements spécifiques. Les fumeurs, les personnes âgées, les sujets de plus de 45 ans avec une pathologie cardiaque et/ou respiratoire chronique, les nourrissons, les femmes enceintes, les sujets obèses (IMC>40) ou profondément immunodéprimés sont les plus à risque de formes graves de la grippe.
ENVIRONNEMENT ( Sept bonnes nouvelles pour le climat et la planète passées inaperçues en 2024 )
En 2024, les hommes n’ont pas réussi à freiner le réchauffement de la planète. Mais d’autres initiatives en faveur du climat ont fonctionné, et elles méritent d’être mises en lumière, comme l'a fait la BBC.
-On ne peut pas se voiler la face. L’année 2024 a été particulièrement sinistre pour la nature et le climat. Nous avons dépassé le seuil de 1,5°C de réchauffement durant 12 mois consécutifs, les catastrophes naturelles, dont le cyclone qui a ravagé Mayotte le 14 décembre, se sont faits plus intenses. Mais il y a tout de même quelques victoires, assure la BBC. Le média britannique liste ainsi sept bonnes nouvelles, parfois passées sous les radars cette année, et qui méritent d’être célébrées.
La première bonne nouvelle, c’est la fin des centrales à charbon au Royaume-Uni. Le 30 septembre dernier, la centrale de Ratcliffe-on-Soar s’est arrêtée de tourner. Elle va désormais être démolie et transformée en autre chose – peut-être en espace de stockage pour batterie électrique. Le pays ne produit donc plus du tout son électricité grâce à l’énergie fossile. En France, les deux centrales thermiques restantes fonctionnent encore quelques jours par an pendant l’hiver. Celle de Saint-Avold, en Moselle, prépare sa reconversion grâce à la biomasse, rapporte La Tribune.
-Des pas dans la bonne direction pour le climat
Il y a encore de quoi se réjouir sur le plan énergétique en 2024. Les sources d’énergie renouvelables n’ont jamais été autant utilisées dans le monde. L'Agence d’information sur l’énergie américaine a noté que, pour la première fois, la production d’énergie éolienne a dépassé la production d’énergie thermique (à base de charbon) aux États-Unis, en avril.
L’agence internationale de l’énergie (IEA) prédit, elle, une multiplication par 2,7 des capacités en énergie renouvelable d’ici 2030. Et cela s’explique notamment par les actions mises en place par la Chine. Pour des raisons économiques plus qu’idéologiques selon l’IEA, Pékin a choisi de miser massivement sur l’énergie solaire. La Chine devrait ainsi produire la moitié des capacités en énergie renouvelable en 2030.
La nature a également eu droit à des éclaircies cette année. Plusieurs espèces et éléments ont obtenu le statut de personne légale. Les monts Te Papakura o Taranaki, en Nouvelle-Zélande, les vagues de la ville côtière de Linhares au Brésil, les baleines et les dauphins de cette même région sont officiellement devenus des personnes. Ils ont désormais des droits qui assurent leur protection.
Terre et mer en danger mais de plus en plus protégées
Dans l’Atlantique, c’est une partie de l’océan qui est maintenant protégée. Les Açores ont créé une nouvelle Aire marine protégée autour de leur archipel. 287 000 km² de mer sont donc désormais inviolables, ni par la pêche, ni par quelconque extraction minière. Cette zone renferme neuf cheminées hydrothermales, conséquences de mouvements de plaques tectoniques, 28 espèces de mammifères marins et 560 espèces de poissons.
-La forêt amazonienne a encore un peu été épargnée cette année. Le poumon de la Terre fait face à une déforestation massive et souvent illégale depuis de très nombreuses années. Mais en 2024, pour la neuvième année d’affilée, la part de forêt détruite a baissé. Pas de quoi sauter au plafond néanmoins : 6 288 km² ont été déboisés, ce qui équivaut à l’intégralité de l’État américain du Delaware, selon l’Institut de recherche brésilien. Le président Lula a promis de mettre un terme à la déforestation d’ici 2030.
Les actions locales et citoyennes sont essentielles pour la préservation de la planète
Deux formes d’initiatives se sont avérées payantes pour la biodiversité cette année. La première, ce sont les programmes de conservation. Les scientifiques ont prouvé qu’ils permettaient de renverser la tendance. Au Kazakhstan, l’initiative Altyn Dala a permis de sauver l’antilope saïga. Alors que l’espèce ne comptait plus que 20 000 individus en 2003, les derniers recensements font état de 2,86 millions d’animaux dans les steppes kazakhes.
En Californie, c’est l’engagement des peuples autochtones en faveur des animaux et de la nature qui a permis le changement. La tribu Yurok a milité pour la destruction d’un barrage sur la rivière Klamath. Moins de deux mois après, en octobre, les saumons étaient de retour dans les eaux de Californie et de l’Oregon. La même tribu travaille à la réintroduction du Condor de Californie dans l’État américain. En octobre, les activistes ont dénombré 18 condors en liberté sur le territoire Yurok, alors qu’ils avaient quasiment disparu.
décembre 19, 2024
L'HOMME ET LA VIE ( Verrue plantaire : photo, morte, noire, comment l'enlever ? )
Avec ses points noirs en son centre, la verrue plantaire (verrue du pied) est fréquente, bénigne mais aussi disgracieuse. Pommade cochon, cryothérapie, remèdes naturels... Il existe plusieurs traitements pour en venir à bout.
_Sommaire
Définition
Photos
Verrue plantaire morte
Symptômes
Verrue ou cor au pie
Cause
Contagieuse ?
Traitement
Pommade cochon
Cryothérapie
Remèdes naturels
Azote liquide chez le dermatologue
Prévention
-La verrue plantaire est une lésion de la peau sur le pied provoquée par une infection virale (virus HPV). Les verrues plantaires touchent de 7 à 10% de la population générale et affectent plus particulièrement les enfants et les adolescents, avec un pic de fréquence entre 10 et 14 ans. Pourquoi a-t-on des verrues plantaires ? Quels sont les lieux à risque ? Les piscines ? Comment s'en débarrasser ? Soi-même à la maison ? Naturellement ? Avec un traitement en pharmacie ? De la pommade cochon ? Des huiles essentielles ? L'azote ?
C'est quoi une verrue plantaire ?
Les verrues sont des lésions bénignes de l'épiderme, qui se manifestent sous la forme d'excroissances rugueuses, logées sur différentes parties du corps. "Les verrues plantaires sont généralement localisées sur la corne et les orteils, plus rarement sur la peau plus fine de la voûte plantaire" informe le Dr Dominique Penso-Assathiany, dermatologue, membre de la Société Française de Dermatologie. Il existe deux types de verrues plantaires :
-La myrmécie : elle se caractérise par la présence d'un anneau dit "kératosique" (épaississement délimité de l'épiderme), dont le centre est piqueté de points noirs. La myrmécie est en général unique ou comprend seulement quelques unités (moins de 4).
Les verrues en mosaïque : elles forment un ensemble de verrues plus superficielles.
Photos d'une verrue plantaire
La verrue plantaire se caractérise par une surface rugueuse avec un surplus de peau épaisse et des petits points noirs au centre (voir la photo ci-dessous), qui correspondent à des petits vaisseaux sanguins qui ont éclaté.
-Comment savoir si la verrue plantaire est morte ?
Lorsque la verrue plantaire est morte, elle laisse place à une couche de peau morte (couche blanche) qui tombera naturellement. La cicatrisation viendra résorber le trou.
Si elle gratte, elle devrait bientôt disparaître.
Quels sont les symptômes d'une verrue plantaire ?
Le plus souvent, les verrues plantaires apparaissent sous la forme de petites excroissances de peau rugueuses au toucher. Les symptômes des verrues plantaires dépendent du type de verrue. "La myrmécie est un rond de peau avec des points noirs dedans. C'est une verrue profonde et souvent douloureuse lors de l'appui du pied, informe la dermatologue. Les verrues en mosaïque sont des verrues plus petites, regroupées en plaque, superficielles et non douloureuses." Les verrues ne grattent pas. "Si une verrue gratte, c'est qu'il y a une inflammation, et c'est souvent le signe qu'elle va bientôt disparaître".
Quelle est la différence entre une verrue et un cor au pied ?
Les verrues peuvent être confondues avec des cors, des durillons. "Le seul moyen d'être certain que c'est une verrue c'est de voir des petits points noirs et parfois les dermatologues doivent gratter pour les voir" explique le Dr Penso-Assathiany. "Le traitement chimique des durillons et des cors et des verrues est le même donc le diagnostic n'est pas essentiel."
-Cause d'une verrue plantaire
Les verrues plantaires à l'instar des autres verrues sont liées à différents types de virus de la famille du virus du papillomavirus humain (HPV), et sont donc contagieuses. Cependant, le risque de contagion est faible. "Il existe 120 sous-types de ce virus. Nous sommes porteurs de 5 à 7 sous-types sur notre peau ou nos muqueuses. Les verrues sont dues soit à un de ces virus soit à un virus présent chez quelqu'un d'autre qui pénètre dans notre peau par l'intermédiaire d'un micro-traumatisme" précise la spécialiste. La transmission nécessite une porte d'entrée, qui est le plus souvent une légère lésion cutanée au pied (ampoule, coupure).
-La verrue plantaire est-elle contagieuse ?
Oui. Cependant, le risque de contagion est faible.
"Il n'y a pas de traitement contre le virus et le risque de récidive est important"
Quel est le traitement pour se débarrasser d'une verrue plantaire ?
Dans la majorité des cas, chez les personnes en bonne santé, les verrues plantaires guérissent spontanément, dans un intervalle allant de quelques mois à 2 ans. "C'est surtout le cas chez les adultes, un peu moins chez les enfants" précise le Dr Dominique Penso-Assathiany. Mais leur contagiosité (faible rappelons-le), et les douleurs qu'elles entraînent parfois, peuvent justifier un traitement approprié pour pouvoir s'en débarrasser. "Il n'y a pas de traitement contre le virus et le risque de récidive est important" précise cependant la dermatologue.
Verrue plantaire chez l'enfant : que faire ?
Rares sont les enfants à ne pas avoir de verrues plantaires. Quelles sont les causes des verrues sur les pieds ? Comment les reconnaître ? Infos et traitements.
Pommade cochon et solutions décapantes
Les traitements de premier choix des verrues plantaires sont ceux décapants les verrues à base d'acides organiques (acide salicylique, acide trichloroacétique, acide formique). Ces préparations exfolient la verrue jour après jour et détruisent localement les cellules infectées par le virus HPV. "Pour traiter les verrues situées au niveau des pieds, il faut choisir des solutions fortement dosées en acide salicylique, par exemple la pommade MO Cochon®, constituée de suif de bœuf avec 50% d'acide salicylique. Attention, elle est très caustique et cela nécessite de protéger la peau autour" prévient le Dr Dominique Penso-Assathiany.
Mode d'emploi : entourez la verrue avec un vernis, posez la pommade, couvrez avec un pansement plastifié ; deux fois par semaine, limez la surface de la verrue avec un bout de lime en carton, à jeter après usage et appliquez la solution kératolytique. Ces traitements décapants ne sont pas douloureux et les effets secondaires sont rares.
Pommade cochon : utilisation, verrue, danger, âge minimum
La pommade cochon est un médicament indiqué pour le traitement local des verrues notamment. Quelle est son efficacité et comment faut-il l'appliquer ? Les réponses avec la dermatologue Marie-Estelle Roux.
Cryothérapie pour détruire la verrue le froid
Autre traitement courant des verrues plantaires disponible en pharmacie, la cryothérapie ou destruction par le froid. La surface de la peau est gelée de l'extérieur par l'application 20 à 40 secondes d'une éponge ou applicateur en mousse contenant un mélange de diméthyléther, et de propane qui forment ensemble un gaz atteignant une température d'environ -50 degrés. La cryothérapie vendue en pharmacie est plutôt efficace sur des verrues plantaires pas très épaisses. C'est une technique plus rapide - une seule application peut suffire sur des verrues peu importantes- mais qui a l'inconvénient d'être douloureuse. Elle est ainsi à éviter chez les enfants.
Bicarbonate, homéopathie : les remèdes naturels contre les verrues
Quant aux remèdes maison des verrues, comme l'application de bicarbonate de soude, de bave d'escargot, ou encore les remèdes alternatifs comme l'homéopathie, "il n'y a aucune preuve scientifique que cela puisse traiter les verrues" informe le Dr Dominique Penso-Assathiany.
10 remèdes de grand-mère contre les verrues
Pansement, ail, citron, banane, plante... Il existe de nombreuses recettes-maison à tester pour faire partir une ou plusieurs verrues. Zoom sur 10 d'entre elles.
Bistouri et azote liquide chez le dermatologue
Si vous avez une verrue plantaire particulièrement résistante, "le dermatologue peut la découper avec une lame de bistouri pour mieux la décaper. C'est sans douleur". Les traitements locaux sont plus efficaces après ce décapage. En revanche, le traitement à l'azote liquide n'est pas plus efficace que les solutions kératolytiques fortement dosées. "Les études ont montré une efficacité identique entre la pommade MO Cochon® et l'azote liquide sur le long terme" explique la dermatologue.
Prévention : comment éviter d'avoir une verrue plantaire ?
"Le lieu le plus transmetteur est probablement la salle de bain familiale" prévient le Dr Dominque Penso-Assathiany, Et non pas comme on le dit souvent la piscine ! Pour prévenir la transmission familiale des verrues, il est recommandé de :
Ne pas échanger les serviettes de toilette
Désinfecter la baignoire ou la douche avec un produit désinfectant contenant de l'Eau de javel.
Bien se sécher les pieds après un contact avec des sols humides de lieux collectifs. Le port de chaussures en plastique n'a pas démontré d'efficacité. De manière générale, le fait de garder vos pieds propres, secs et bien hydratés (en mettant une crème hydratante régulièrement) prévient les verrues.
Si vous avez une lésion au niveau du pied, vous pouvez porter un pansement étanche pour prévenir la pénétration éventuelle du virus.
Lorsque vous avez une verrue, il est recommandé de vous laver les mains après l'avoir touchée, pour éviter les risques d'auto-transmission.
Durant le traitement, vous pouvez couvrir votre verrue avec un pansement.
décembre 18, 2024
L'HOMME ET LA VIE ( Hypertrophie musculaire : comment prendre de la masse ? )
L'hypertrophie musculaire se définit par l'augmentation de la taille des muscles. Déclenchée par un entraînement de force avec une résistance (poids), elle est liée à la musculation. Est-ce un signe de bonne santé ? Comment la maximiser ? Et quelles sont les précautions à prendre ?
Sommaire
Définition
Causes
Signe de bonne santé
Maximiser l'hypertrophie musculaire
Risques et précautions à prendre
-Définition : c'est quoi l'hypertrophie musculaire ?
"L'hypertrophie est un terme général qui désigne une augmentation du volume d'un organe ou d'un tissu par l'agrandissement des cellules qui le composent, précise Alexandre Saidani, kinésithérapeute. Dans le cadre d'une hypertrophie musculaire, il s'agit de l'épaississement des fibres musculaires de Type II (connues aussi sous le nom de fibres à contraction rapide) qui va permettre de créer des muscles plus gros et plus forts". Cette augmentation est induite par un entrainement intensif contre une résistance.
Quelles sont les principales causes de l'hypertrophie musculaire ?
"On distingue trois principaux facteurs qui sont susceptibles d'initier l'hypertrophie musculaire, assure Thomas Geraci, kinésithérapeute : les lésions musculaires, la tension mécanique et le stress métabolique".
► Dans le cadre d'un entrainement, l'hypertrophie musculaire est la conséquence de la sollicitation d'un ou de plusieurs muscles face à une résistance suffisante, pour créer volontairement des lésions aux fibres musculaires. Ces lésions seront réparées dans les jours suivant l'entraînement par les protéines. Ces dernières vont permettre d'augmenter la résistance des fibres musculaires et de s'adapter aux prochains stress musculaires.
► "De plus, la tension mécanique provoquée par les contractions et les étirements face à la résistance vont augmenter la masse musculaire alors que l'absence d'exercice se traduit par l'atrophie".
► Enfin, de nombreuses études soulignent l'importance du stress métabolique dans la prise de masse musculaire. "Le stress métabolique apparaît lorsque nous augmentons les charges de travail sur un muscle ou un certain groupe de muscles. Lorsque les muscles commencent à "brûler", cela entraîne une augmentation progressive de la croissance musculaire".
Est-ce le signe de bonne santé ou de maladie ?
"Si l'on parle d'hypertrophie ventriculaire (épaississement du muscle de la cavité inférieure (ventricule) du cœur) par exemple, il s'agit d'une maladie qui va nécessiter un traitement, poursuit Thomas Geraci. En revanche l'hypertrophie musculaire est un signe de bonne santé et d'activité physique régulière".
Comment maximiser l'hypertrophie musculaire ?
Il n'existe pas de formule magique pour maximiser l'hypertrophie musculaire car chaque personne est différente. "Tout repose néanmoins sur un entrainement à intensité modérée, reprend Alexandre Saidani. Il s'agit là de travailler entre 8 et 12 mouvements, en série de 4, à 60/70% environ du poids de notre répétition maximale RM (c'est-à-dire la charge maximale que l'on peut soulever en une fois) ". Cet entrainement devra inclure une amplitude de mouvement la plus grande possible pour étirer le muscle, l'aidant à prendre du volume sur toute sa longueur. Cependant, la littérature récente montre un éventail beaucoup plus large d'options d'entraînement, rappelle le blog scientifique professionnel NeuroXtrain. Plusieurs études ont montré que l'entraînement avec de faibles charges (30-60% RM) entraîne une hypertrophie similaire à l'entraînement avec des charges modérées et élevées (> 60% RM) en cas d'échec volontaire (ou musculaire). Par ailleurs, il a été établi que le volume de RT, défini comme le nombre total de répétitions (répétitions x séries), associé aux charges utilisées pour un exercice donné, est l'élément clé de l'adaptation en termes d'hypertrophie musculaire ; de plus, il a été suggéré que des volumes d'effort plus élevés sont justifiés pour maximiser la réponse de croissance musculaire dans diverses populations. La nutrition est également un facteur important pour que l'hypertrophie musculaire se déclenche vraiment. "Elle aide à la récupération après l'effort et permet d'enchainer les séances". Privilégier notamment les protéines après l'entraînement et buvez beaucoup d'eau (minimum 3 litres/jour).
Le faire seul est risqué car le patient peut mal faire ses mouvements
Quels sont les risques et précautions à prendre ?
"L'hypertrophie musculaire nécessite une prise en charge multidisciplinaire avec le médecin, le nutritionniste/diététicien, le kiné et éventuellement le coach sportif, insiste Thomas Geraci. Le faire seul est risqué car le patient peut mal faire ses mouvements, en faire trop et trop fort ce qui peut créer de nouvelles lésions (inflammations, tendinites, déchirures…). En tant que kiné, nous allons travailler sur l'hypertrophie musculaire afin de redonner à un patient, en rééducation après une chirurgie orthopédique ou une blessure, une autonomie musculaire". Dans tout processus de renforcement musculaire, il est important d'avoir une bonne hygiène de vide, du repos et de bien s'échauffer avant tout effort.
L'HOMME ET LA VIE ( Faire du sport quand on est malade, une mauvaise idée ? )
Est-ce que le sport permet de guérir plus vite ou l'inverse ?
-C'est un fait, l'exercice physique permet de renforcer le système immunitaire et de prévenir la survenue de maladies. Dès lors, il semble naturel de penser que le sport peut aider à "décrasser" l'organisme quand on est malade. En réalité, c'est plus une question de bon sens et de ressenti. "Tout dépend de la maladie et du type de sport", pose d'emblée le Dr Alexandra Dalu, ancienne urgentiste. "En cas de blessure de type fracture, il est évident qu'il va falloir attendre que la fracture se répare pour pouvoir reprendre une activité physique."
S'il s'agit d'une infection ORL (rhume, toux, sinusite), mieux vaut éviter de faire du sport dans les premiers temps pour laisser l'organisme se défendre. Il lutte tellement contre les microbes que généralement, on se sent épuisé et que le moindre effort nous coûte. Dans ce contexte, faire du sport se révélerait contre-productif puisqu'on n'a pas suffisamment d'énergie pour être performant et que cela ne nous fera pas guérir plus vite. Évidemment, tout dépend de l'état de chacun. En cas de gêne légère, il est tout à fait possible de pratiquer une activité douce comme la marche. "Le fait de s'aérer et de se mettre en mouvement stimule notre immunité et la production de protéines antidouleurs, ce qui ne peut que se révéler bénéfique", argue le Dr Alexandra Dalu.
En cas de gastro-entérite ou de grippe, la question de faire du sport ne se pose même pas. D'une part parce qu'on ne dispose pas de l'énergie nécessaire pour pratiquer une activité physique, et d'autre part, parce que l'on risque d'aggraver son état de déshydratation. Il est préférable de s'octroyer une petite pause, de laisser à son corps le temps de récupérer, et de reprendre plus tard, quand on sera bien remis. "De manière générale, on sait que les sportifs tombent moins souvent malades que la moyenne de la population générale et qu'ils récupèrent plus vite", commente le Dr Alexandra Dalu.
"En cas d'otite ou de sinusite, il faut évidemment éviter de mettre sa tête sous l'eau parce qu'il ne faut pas que l'eau entre en contact avec le tympan et les sinus, la natation est donc contre-indiquée. Dans les autres situations, il est possible de faire le sport que l'on aime si on se sent bien mais si on souffre d'une pathologie avec un peu de fièvre, il est quand même assez rare d'avoir envie de faire du sport", continue-t-elle.
-En cas de cancer, la fatigue engendrée par le traitement (chimiothérapie, radiothérapie, immunothérapie, chirurgie) est susceptible d'annihiler l'envie de faire du sport. "Mais si on se sent d'attaque, il est toujours recommandé de faire le sport que l'on aime, surtout quand il s'agit de maladies chroniques", insiste notre interlocutrice.
AGRICULTURE ( Plantation du tournesol : Date semis et entretien du tournesol )
Si vous voulez faire sensation au jardin... plantez des tournesols ! Vous trouverez autant de tailles différentes, de naines à géantes, que de couleurs : en plus des classiques à fleurs jaunes, il existe des tournesols rouges, orange ou même blancs.
Les tournesols (Helianthus annuus) sont idéals pour initier les enfants au jardinage, et ils conviennent parfaitement aux jardins favorisant la biodiversité.
-Planter et cultiver des tournesols
Les meilleurs tournesols à planter
Il y a plus de 70 variétés différentes de tournesol. Les variétés naines ne dépassent pas 50 cm de haut, alors que les plus grandes peuvent atteindre plus de 3 mètres. Voici quelques-unes de nos favorites :
Les tournesols géants :
Tournesol ‘Russian Giant’ – 3 m de haut, avec des fleurs jaune lumineux.
Les grands tournesols :
Tournesol ‘Velvet Queen’ – 1,8 m de haut, aux fleurs rouges spectaculaires.
Tournesol ‘Earth Walker’ – 1,8 m de haut, dans des tons bronze, orange et jaunes.
Tournesol ‘Red Sun’ – 1,8 m de haut, inflorescence rouge foncé et cœur presque noir.
Tournesol ‘Valentine’ – 1,5 m de haut, aux fleurs jaune crème.
Les tournesols nains :
Tournesol ‘Teddy Bear’ – 50 cm de haut, aux fleurs jaunes doubles en pompon.
Tournesol ‘Dwarf Yellow Spray’ – buisson de 60 cm de haut avec des fleurs jaunes.
-Où planter les tournesols ?
Les tournesols ont deux besoins vitaux : un sol fertile et beaucoup de soleil. Une fois que vous avez rempli ces conditions, vous pouvez lâcher la bride à votre imagination :
Plantez les variétés naines en pot et créez votre style « Van Gogh » à la maison. Si vous avez la place pour, pourquoi ne pas border une allée de tournesols ? Ou, plus simplement, plantez vos tournesols en masse dans vos massifs pour offrir un magnifique spectacle en été.
L’équipement essentiel pour la plantation de tournesol
Pour la culture des tournesols au jardin, vous aurez besoin de :
Graines de tournesol
Un râteau
Un transplantoir
Des pots
Du terreau pour fleurs
Des sacs en plastique transparent ou du plastique transparent
Quand et comment planter des tournesols ?
Semez des tournesols sous abri en avril et repiquez-les en pleine terre en mai lorsque tout risque de gelée est écarté. Suivez ces étapes pour de superbes fleurs estivales :
Remplissez des petits pots avec du terreau de semis.
Plantez une graine par pot à 1,5 cm de profondeur.
Arrosez les pots et recouvrez-les de plastique transparent.
Placez les pots dans un endroit clair et frais, par exemple sur un rebord de fenêtre qui ne reçoit pas le soleil directement.
Une fois que les graines ont germé, enlevez les protections plastique. Gardez le terreau humide.
Endurcissez vos semis en les sortant pendant deux semaines le jour et les rentrant la nuit.
Avant de repiquer en pleine terre, désherbez le sol, et enfouissez du compost ou du fumier bien décomposé pour enrichir la terre.
Espacez les plants d’environ 45 cm.
Arrosez bien après la plantation.
Vous pouvez aussi planter les tournesols en pleine terre fin mai. Voici comment faire :
Débarrassez le sol des mauvaises herbes et enfouissez du fumier ou du compost dans la terre.
Ratissez le sol pour obtenir une terre friable et légère.
Semez à 1,5 cm de profondeur et en respectant 10 cm d’écart, puis arrosez bien.
Une fois que les pousses sont sorties, éclaircissez-les pour obtenir un écart de 45 cm entre les plants.
Cultiver les tournesols pour les bouquets
Si vous cultivez des tournesols pour vos compositions florales, vous aurez besoin de plants buissonnants qui produiront un maximum de fleurs. Pour créer un buisson fleuri, vous pouvez pincer les extrémités des plants (l’ensemble de feuilles au sommet de la plante). Le tournesol réagira en créant des tiges latérales fleuries.
Pour les grands tournesols, pincez les extrémités lorsque les plants atteignent 20 cm.
Couper ou pincer les extrémités des tournesols nains lorsqu’ils font 10 à 15 cm de haut, en ne laissant que deux paires de feuilles sur la tige. Recommencez lorsque la plante aura encore grandi de 7 à 10 cm.
-Comment entretenir vos tournesols ?
Suivez les étapes suivantes pour apporter à vos tournesols tout le soin et l’attention qu’ils méritent.
Tuteurez les grands tournesols au fur et à mesure qu’ils grandissent.
Dès l’apparition des fleurs, apportez un engrais riche en potasse une fois par semaine (un engrais rapide plantes fleuries convient tout à fait).
Arrosez régulièrement pendant les périodes sèches, particulièrement les variétés hautes, car il leur est compliqué de se remettre après un coup de chaud.
Méfiez-vous des limaces et escargots qui dévorent les jeunes pousses. Protégez les pots avec du paillage de chanvre, ou épandez des granulés anti-limaces (utilisable en agriculture biologique) qui respectent aussi les autres animaux.
Lorsque les fleurs sont fanées, laissez les têtes sur place. Les oiseaux comme les pinsons et moineaux en raffolent.
En fin d’automne, déterrez les plants et compostez-les.
Comment récolter les graines de tournesol ?
Pour récolter les graines, attendez que les pétales commencent à tomber. Vous aurez peut-être besoin de recouvrir les fleurs d’un filet pour les protéger de l’appétit des oiseaux.
Coupez les fleurs en prévoyant une longueur de tige conséquente.
Mettez les fleurs dans un sac en papier et suspendez les tournesols pour les faire sécher dans un local chaud et bien aéré pendant quelques semaines.
Une fois les graines sèches, détachez-les à la main de la tête.
Conservez les graines dans un contenant hermétique.
Comment lutter contre les ennemis et maladies du tournesol ?
Limaces
Outre les mollusques (limaces et escargots) qui raffolent des tournesols, les tournesols peuvent aussi souffrir du mildiou et de l’oïdium.
Mildiou
Le mildiou, un champignon, se caractérise par des marbrures brunes sur les feuilles et se développe par temps humide. Un traitement à base de cuivre peut en venir à bout, mais aussi une solution diluée de bicarbonate de soude.
Oïdium ou blanc
L’oïdium ou « blanc » laisse un duvet blanc sur les feuillages. Agissez en amont en espaçant les plants et en ôtant aussitôt les parties infectées, et traitez soit avec le bicarbonate de soude, soit avec du soufre.
Petites anecdotes autour du tournesol…
Planter et cultiver des tournesols
Le record du tournesol le plus haut date de 2014, et est détenu par une fleur allemande de 9,17 mètres.
Le disque central de la fleur est composé de minuscules fleurs uniques. Les pétales qui les entourent ont pour vocation d’attirer les pollinisateurs au centre du tournesol.
Les tournesols sont dits « héliotropes » - cela signifie qu’ils suivent la course du soleil, de sorte que les bourgeons floraux lui font toujours face. Une fois épanouis, les tournesols ont la tête trop lourde et ne peuvent plus réellement bouger en fonction de l’ensoleillement.
Si les tournesols ne sont pas pollinisés par des insectes, ils peuvent s’auto-féconder. Chaque petite fleur du disque central est capable de courber son stigmate et de transférer le pollen à l’anthère de la fleur, qui se transformera ensuite en graine.
ENVIRONNEMENT ( Reenchanter La Nuit )
Contre la pollution lumineuse : "Réenchanter la nuit" pour préserver la faune urbaine
La pollution lumineuse est un phénomène insidieux qui transforme nos nuits en une perpétuelle semi-clarté, perturbant non seulement notre perception du ciel étoilé mais aussi l’équilibre fragile de la faune urbaine.
L'impact de la pollution lumineuse sur la biodiversité
Chaque nuit, les lampadaires, enseignes lumineuses, et éclairages de sécurité contribuent à la diffusion d'une lumière artificielle à grande échelle. Ce surplus d'éclairage perturbe les cycles naturels de nombreuses espèces animales qui dépendent de l’obscurité pour s’orienter, se reproduire ou trouver leur nourriture.
Les insectes, par exemple, sont attirés par la lumière artificielle et finissent souvent par s'épuiser ou devenir des proies faciles. Les oiseaux migrateurs, eux, sont déroutés par les faisceaux lumineux des villes, ce qui les expose à des collisions mortelles.
Des conséquences également visibles sur l’humain
La pollution lumineuse n’affecte pas que la faune. Pour les citadins, elle altère la qualité du sommeil et peut entraîner des problèmes de santé tels que des troubles du rythme circadien. En outre, elle efface peu à peu notre lien avec la nature, privant les jeunes générations du spectacle émerveillant des étoiles.
"Réenchanter la nuit" : des solutions simples et efficaces
Pour contrer la pollution lumineuse, il est essentiel de réduire l’éclairage artificiel, tout en garantissant la sécurité et le confort des habitants. Voici quelques pistes à explorer :
Installer des éclairages directionnels : Cela limite la dispersion inutile de lumière vers le ciel.
Réguler les horaires d’éclairage : En éteignant les lumières non essentielles la nuit, les communes réduisent également leur consommation d’énergie.
Privilégier des ampoules LED à basse intensité : Ces dernières émettent moins de lumière bleue, nocive pour la faune et l’humain.
Sensibiliser les citoyens : Encourager les habitants à éteindre leurs luminaires extérieurs inutiles peut faire une grande différence.
Un enjeu écologique et culturel
Réenchanter la nuit, c’est redécouvrir la magie des cieux nocturnes et respecter les besoins vitaux des espèces qui partagent notre espace urbain. De nombreuses villes, comme Paris ou Lyon, ont déjà adopté des politiques d’éclairage raisonné, réconciliant ainsi modernité et respect de l’environnement.
Face à cet enjeu mondial, chacun peut jouer un rôle. En modifiant nos habitudes et en soutenant des initiatives locales, nous pouvons non seulement protéger la biodiversité mais aussi nous reconnecter à la beauté de la nuit.
ENVIRONNEMENT ( "Les Yeux de la Mer : Comment les Algues Océaniques Utilisent un Organe Insoupçonné pour Percevoir la Lumière" )
Les secrets lumineux des algues marines dévoilés
Les algues marines, essentielles à l'équilibre des écosystèmes océaniques et à la production d'oxygène, n'ont pas fini de nous surprendre. Une récente étude menée par le CNRS révèle une découverte fascinante : certaines algues disposent d'un organe jusque-là insoupçonné, leur permettant de détecter la lumière de manière étonnamment sophistiquée.
Un système sensoriel unique
Ces organismes marins, bien qu'ils ne possèdent pas d'yeux à proprement parler, utilisent une structure spécialisée agissant comme une forme rudimentaire d’organe sensoriel. Ce système leur permet de percevoir et de répondre à leur environnement lumineux avec une précision remarquable. Cette adaptation est cruciale, car la lumière joue un rôle clé dans leur photosynthèse et leur survie dans des conditions marines parfois extrêmes.
Une avancée scientifique majeure
Grâce à des techniques d'imagerie et d'analyse moléculaire de pointe, les chercheurs ont identifié un mécanisme de détection de la lumière qui diffère de tout ce que l'on connaît chez les plantes terrestres. Ce mécanisme pourrait ouvrir la voie à de nouvelles applications biotechnologiques, comme l’amélioration des rendements en biomasse ou la conception de nouveaux capteurs optiques inspirés par la nature.
Pourquoi cette découverte est importante
Outre son intérêt scientifique, cette étude soulève des questions fascinantes sur l'évolution des mécanismes sensoriels dans le règne végétal. Comment ces algues ont-elles développé un organe aussi performant dans des environnements souvent pauvres en lumière ? Et quelles implications cela pourrait-il avoir pour la compréhension des premiers organismes photosynthétiques sur Terre ?
En révélant ces "yeux" de la mer, le CNRS nous invite à repenser notre compréhension des capacités adaptatives des organismes marins. Une fois encore, la nature nous rappelle qu’elle est une source infinie d’inspiration et de découvertes.
Le "poumon" de la Terre a lui-même des "yeux" ! Produisant par photosynthèse la moitié de l'oxygène sur notre planète, soit davantage que l'ensemble des forêts, le plancton végétal (phytoplancton) se répartit dans l'océan selon des mécanismes que l'on peine encore à saisir. L'un d'entre eux vient d'être identifié : il s'agit de la lumière.
Des scientifiques du CNRS et de Sorbonne Université l'ont découvert en étudiant les capacités sensorielles des diatomées. Ces minuscules algues brunes sont des "orfèvres en fabrication de verre à température ambiante", comme en témoigne leur squelette externe translucide aux formes et aux motifs immensément variés (Muséum national d'Histoire naturelle).
Publiée dans la revue Nature le 18 décembre 2024, l'étude menée par cette équipe française révèle en effet que ces organismes marins possèdent des capteurs de variations lumineuses, appelés "phytochromes" (communiqué).
Percevoir la lumière, là où la longueur du jour varie
Codifiés dans leur génome, ces organes leur permettent de détecter les changements du spectre lumineux dans la colonne d'eau et ainsi de les "informer sur leur position dans cette colonne", expliquent les chercheurs. Pourtant, ce n'est pas le cas partout !
Grâce à l'analyse des données génomiques recueillies à l'aide de prélèvements d'eau réalisés lors des expéditions Tara Océan, les auteurs de l'étude ont en effet remarqué que seules les diatomées des zones au-delà des tropiques du Cancer et du Capricorne semblent posséder des phytochromes.
Ces régions étant caractérisées par des "saisons marquées" et de "fortes différences de longueur du jour", les scientifiques en déduisent que cet organe aide probablement les diatomées qui en sont pourvues à "mesurer le passage du temps".
Cette perception de la lumière s'avérerait ainsi "particulièrement importante" pour ajuster leur activité biologique – en particulier l'intensité de leur photosynthèse – dans des "environnements aquatiques changeants" soumis à d'importants brassages d'eau (hautes latitudes, régions tempérées et polaires).
Oxygène, azote, carbone… La révolution des diatomées
En apportant un "nouvel éclairage" sur la façon dont les algues se repèrent à l'aide de la lumière, l'étude met en évidence la nécessité de mener des recherches "intégrées", à la fois en laboratoire et en milieu naturel, pour "mieux appréhender les dynamiques complexes des écosystèmes océaniques" ainsi que la "capacité des organismes marins à répondre aux changements environnementaux" (communiqué).
Conclusion : Les algues océaniques, ces sentinelles des écosystèmes marins, n'ont pas fini de nous étonner. Cette découverte renforce l'importance de préserver leur habitat naturel, non seulement pour leur rôle écologique, mais aussi pour les secrets qu'elles continuent de révéler au monde scientifique.
L'HOMME ET LA VIE ( Les bactéries miroir : une nouvelle menace pour l'humanité )
La recherche scientifique explore constamment de nouvelles frontières, et la création de "bactéries miroir" en est une illustration récente. Ces organismes synthétiques, dont la structure moléculaire est inversée par rapport à celle des formes de vie naturelles, suscitent des débats passionnés au sein de la communauté scientifique. Bien qu'elles offrent des perspectives innovantes, elles posent également des questions cruciales quant à leur impact potentiel sur la santé humaine et les écosystèmes.
Qu'est-ce que la "vie miroir" ?
Dans la nature, les molécules biologiques existant souvent sous deux formes disent "chirales", semblables à des images miroir l'une de l'autre. Cependant, la vie sur Terre utilise presque exclusivement une seule de ces formes. La "vie miroir" fait référence à des organismes artificiels construits à partir de la forme opposée de ces molécules. Cette inversion moléculaire pourrait théoriquement conduire à des formes de vie entièrement nouvelles, avec des propriétés et des comportements différents de ceux que nous connaissons.
Les promesses des bactéries miroir
Les chercheurs voient dans les bactéries un potentiel considérable. Elles pourraient être utilisées pour développer des thérapies innovantes, produire des biomatériaux résistants ou encore créer des systèmes biologiques moins susceptibles d'être affectés par les agents pathogènes naturels. Leur structure inversée pourrait également les rendre résistantes à la dégradation par les enzymes naturelles, ouvrant la voie à des applications industrielles durables.
Les risques pour la santé humaine
Cependant, cette innovation n'est pas sans risques. Les défenses immunitaires humaines sont adaptées pour reconnaître et combattre les agents pathogènes naturels. Les bactéries miroir, avec leur structure inversée, pourraient échapper à cette reconnaissance, rendant les infections probables plus dangereuses et difficiles à traiter. De plus, si ces organismes artificiels interagiront éventuellement avec la biologie humaine de manière imprévue, les conséquences pourraient être graves, voire incontrôlables.
Les implications écologiques
L'introduction de bactéries miroir dans l'environnement pourrait également perturber les écosystèmes. Leur résistance à la dégradation naturelle pourrait entraîner une accumulation incontrôlée, affectant les cycles biologiques et chimiques. De plus, leur interaction avec les organismes vivants pourrait provoquer des déséquilibres écologiques, menaçant la biodiversité et la stabilité des habitats naturels.
Appels à la prudence
Face à ces incertitudes, de nombreux scientifiques appellent à une réglementation stricte de la recherche sur les bactéries miroir. Ils soulignent la nécessité d'évaluer rigoureusement les risques potentiels avant toute application pratique. Des discussions sont en cours pour établir des protocoles de sécurité et des cadres éthiques afin de guider ces travaux prometteurs mais potentiellement dangereux.
Conclusion
La création de bactéries miroir représente une avancée scientifique majeure, porteuse de promesses et de défis. Il est essentiel de poursuivre cette recherche avec une vigilance accrue, en équilibrant l'innovation avec la responsabilité, pour protéger la santé publique et préserver l'intégrité de nos écosystèmes.
MONDE D'ANIMAL ( Serval Leptailurus serval )
Le serval (Leptailurus serval) est un félin de taille moyenne que l’on trouve dans les déserts et les savanes à hautes végétations dans diverses régions d’Afrique. Carnivore, il se nourrit de toutes les proies que sa taille lui permet d’attraper.
Sommaire
Taxonomie du serval
Caractéristiques physiques du serval
Performances physiques du serval
Écologie et répartition du serval
Régime alimentaire du serval
Mode de vie du serval
Reproduction du serval
Menaces et conservation du serval
Photos du serval
-Taxonomie du serval
Classification
Règne : Animal
Embranchement/sous-embranchement : Chordé vertébré
Classe/infra-classe : Mammifère placentaire
Ordre : Carnivore féliforme
Famille : Félin féliné
Genre : Leptailurus
Espèce : serval
Nom scientifique : Leptailurus serval
Sous-espèces / taxons
On dénombre 18 sous-espèces de serval (dont 2 éteintes) réparties un peu partout en Afrique (la sous-espèce varie selon la région). Elles sont les suivantes :
Liste des sous-espèces
Serval du Cap (Leptailurus serval serval), éteinte
Serval du Maroc (Leptailurus serval constantinus), probablement éteinte à l’état sauvage
Serval du Mozambique (Leptailurus serval beirae)
Serval d’Afrique de l’Ouest (Leptailurus serval brachyura)
Leptailurus serval faradjius
Leptailurus serval ferrarii
Serval du Transvaal de l’Est (Leptailurus serval hamiltoni)
Serval du Transvaal de l’Ouest (Leptailurus serval robertsi)
Serval de Tanzanie (Leptailurus serval hindei)
Serval d’Ouganda (Leptailurus serval kempi)
Serval de République démocratique du Congo (Leptailurus serval kivuensis)
Serval d’Angola du Nord (Leptailurus serval lipostictus)
Serval d’Angola du Sud (Leptailurus serval lonnbergi)
Serval du Botswana Nord (Leptailurus serval mababiensis)
Leptailurus serval pantastictus
Leptailurus serval phillipsi
Leptailurus serval pococki
Serval du Togo ou serval du Bénin (Leptailurus serval togoensis)
Caractéristiques physiques du serval
Taille
Longueur : 70 à 112 cm
Garrot : 54 à 66 cm
Queue : 30 à 50 cm
Poids
Femelle : 9 à 16 kg
Mâle : 12 à 26 kg
Morphologie et apparence
Le serval est un félin de taille moyenne possédant la silhouette d’un chat, doté d’une agilité unique. En effet, le serval possède un long corps élancé, une queue de taille moyenne, des pattes très puissantes (surtout les pattes arrière) munies de griffes rétractiles, un long cou et une assez petite tête. Ses grandes oreilles sont triangulaires arrondies, et sa tête est très similaire à celle des chats domestiques (vibrisses, crocs coupants, petit museau). Ses petits yeux sont marron jaune.
Son pelage est de couleur sable, avec d’assez grosses taches noires (pois et fines languettes) un peu partout sur le corps. Le dessous de son corps est plus clair (crème blanc), mais est également tacheté. Des cas de mélanisme (fourrure noire) et de leucitisme (robe blanche) ont été rapportés, mais sont très rares.
Performances physiques du serval
Vitesse
Le serval peut courir jusqu’à 80 km/h.
Saut
Le serval possède une très impressionnante capacité de sauteur pour sa taille. En effet, son saut sans élan peut atteindre 3 mètres de haut, 6 mètres en longueur.
Écologie et répartition du serval
Aire de répartition
Le serval vit dans plusieurs pays d’Afrique (surtout subsaharienne).
Liste des pays
Présent :
Afrique du Sud ; Angola ; Bénin ; Botswana ; Burkina Faso ; Burundi ; Cameroun ; Centrafrique ; Congo ; Côte d’Ivoire ; Djibouti ; Érythrée ; Eswatini ; Ethiopie ; Gabon ; Gambie ; Ghana ; Guinée ; Guinée-Bissau ; Kenya ; Liberia ; Malawi ; Mali ; Mozambique ; Namibie ; Niger ; Nigeria ; Ouganda ; Rwanda ; Sénégal ; Sierra Leone ; Somalie ; Soudan ; Tanzanie ; Tchad ; Togo ; Zambie ; Zimbabwe
Probablement éteint :
Maroc ; Algérie ; Lesotho
Éteint :
Province du Cap en Afrique du Sud
Habitat
Le serval vit dans les savanes sèches, les zones semi-désertiques, les savanes inondables et les forêts tropicales.
Régime alimentaire du serval
Type de régime
Uniquement carnivore.
Nourriture et proies
Animal opportuniste, le serval s’attaque principalement à des petites proies comme les rongeurs (rats, souris, lapins) et à d’autres petits mammifères (daman). Il chasse également certains oiseaux, reptiles, grenouilles et insectes. Si ces proies constituent la majorité de son régime, il arrive également qu’il s’attaque à certaines proies plus grandes, comme le dik-dik, l’ourébis ou certaines jeunes antilopes.
Il mange également parfois de l’herbe, excellente pour son transit.
Mode de vie du serval
Vie sociale
Comme la majorité des félins, le serval est un animal solitaire et territorial. En effet, il vit généralement seul dans un territoire, qu’il marque avec son urine jusqu’à 10 fois par heure, qui peut parfois chevaucher celui d’un autre individu.
Les combats entre les différents individus sont rares, ces animaux préférant s’éviter plutôt que de s’affronter. A la saison des amours, ils deviennent cependant plus sociables : les couples formés restent souvent plusieurs jours ensemble.
Seul cas de vie à plusieurs : la mère et ses petits. En effet, la femelle serval élève seule ses chatons à l’abri dans une tanière ou un buisson, et veille sur eux plusieurs mois, au cours desquels de vrais liens se créent. Au bout de cette période, les petits sont chassés, pour permettre à la femelle d’avoir une nouvelle portée.
Comportement
Le serval est un animal polyvalent, qui vit le jour ou la nuit. Il est cependant principalement nocturne et crépusculaire, se reposant et se toilettant le plus souvent à l’abri de la chaleur pendant la journée (dans un buisson ou les hautes herbes). Ce sont des animaux qui bougent beaucoup : ils parcourent généralement 2 à 4 km chaque nuit, notamment pour trouver de quoi se nourrir.
Bien qu’il vive le plus clair de son temps sur terre, il arrive que certains individus grimpent aux arbres ou nagent dans l’eau pour éviter les prédateurs.
Cri et vocalises
Comme le guépard ou le chat, le serval peut ronronner. Il peut également miauler, cracher et grogner, mais est incapable de rugir.
Territoire
La taille du territoire d’un serval varie entre 10 et 32 km2.
Prédateurs
Bien qu’il soit lui même un prédateur, le serval est de par sa petite taille vulnérable face aux léopards, ainsi qu’aux hyènes et aux lycaons (et l’Homme).
Technique de chasse
Possédant de nombreux atouts physiques, le serval est un expert de la chasse. Tout d’abord, il repère sa proie, à l’aide de son ouïe sur développée ou de son long cou qui lui permet de voir par-dessus les hautes herbes. Il la traque ensuite lentement en s’en approchant discrètement. Une fois assez proche et le moment venu (il peut rester sans bouger près de 15 minutes), il bondit sur elle grâce à son excellent détente à l’arrêt et l’attrape avec ses longues pattes en sortant ses griffes.
Il joue ensuite souvent avec sa proie pendant plusieurs minutes, et la tue d’une morsure ou d’un coup de griffe. Contrairement à la plupart des autres félins, le serval possède un très haut taux de réussite : 1 attaque sur 2 (50%) se solde par une capture, contre seulement 1 sur 10 (10%) pour des prédateurs comme le tigre.
Longévité
L’espérance de vie du serval est de :
A l’état sauvage : 10 à 15 ans en moyenne.
En captivité : 20 ans
Reproduction du serval
Type de reproduction
Vivipare
Habitudes reproductives
Polygame
Sevrage
Le sevrage du serval commence à 1 mois, mais le petit est totalement sevré vers 1 an.
Maturité sexuelle
Le serval est sexuellement mature à 1 à 2 ans en moyenne.
Période de reproduction
La saison des amours du serval dépend selon la région où il vit : en hiver au sud de son aire de répartition (Botswana) contre la fin de la saison sèche plus au centre (Tanzanie).
Lieux de mise bas
Dans une tanière, généralement volée à un autre animal (oryctérope du Cap).
Nombre de portées
Jusqu’à 2 portées par an, mais généralement 1 portée par an.
Nombre de petits par portée
La femelle serval met bas à 1 à 4 chatons (2–3 en moyenne), qui naissent les yeux fermés et le corps recouvert de poils duveteux.
Gestation
66 à 77 jours environ.
Taille et poids des petits
250 g à la naissance.
Menaces et conservation du serval
Danger d'extinction (Statut UICN)
Le serval est un animal préoccupation mineure (LC) selon l’UICN.
Le statut varie cependant selon la sous-espèce. Certaines sous-espèces ont même disparu (serval du cap, peut-être serval du Maroc).
Population
Le nombre d’individus à l’état sauvage est inconnu.
La population mondiale de servals est actuellement stable.
Menaces
Les menaces pesant sur le serval sont :
Perte et dégradation de son habitat : agriculture, réchauffement climatique (feux), …
Menaces directes : chasse et braconnage.
S'abonner à :
Messages (Atom)
Message en vedette
ANIMAL WORLD ( Why Colorful Parrots Are Popular Pets: A Guide to Their Vibrant Plumage and Talking Abilities )
Introduction. Parrots are among the most sought-after pets in the world, thanks to their strikingly colorful feathers and remarkable abilit...

-
Le nashi, aussi appelé "poire japonaise", possède plein de bienfaits. Mais comment le manger et dans quelles recettes ? Quelle est...
-
Alors que l'hydrogène vert s'impose comme un pilier de la transition énergétique, sa stockage massif et économique reste un défi de ...